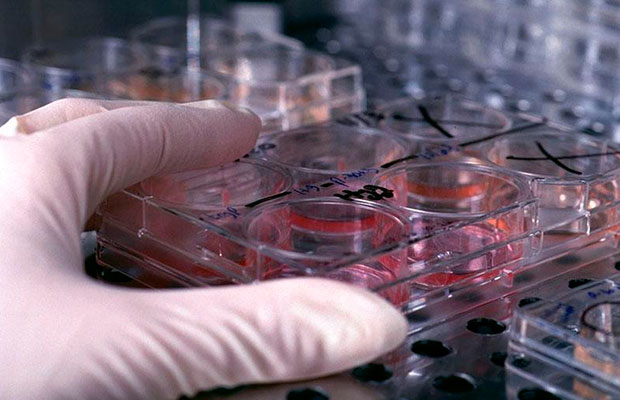

WASHINGTON.- Un equipo de científicos de la Universidad Estatal de Washington (WSU), en Estados Unidos, ha identificado un gen presente en casi todas las especies de mamíferos que podría ser clave para desarrollar un anticonceptivo masculino altamente eficaz, reversible y no hormonal.
En el estudio, el equipo identificó la expresión del gen ‘Arrdc5’, presente en el tejido testicular de ratones, cerdos, bovinos y humanos que, al ser anulado en ratones, produjo infertilidad solo en los machos.
Los detalles se publican hoy en un artículo en Nature Communications.
«El estudio identifica por primera vez que este gen solo se expresa en el tejido testicular, en ninguna otra parte del cuerpo. Se expresa en múltiples especies de mamíferos», afirma Jon Oatley, autor principal y profesor de Biociencias moleculares en la Universidad de Washington.
«Cuando este gen se inactiva o inhibe en los machos, éstos producen espermatozoides que no pueden fertilizar un óvulo; un objetivo primordial para el desarrollo de anticonceptivos masculinos», explica.
Sin efectos hormonales
Aunque se han identificado otras dianas moleculares para el posible desarrollo de anticonceptivos masculinos, el gen ‘Arrdc5’ es específico de los testículos masculinos y se encuentra en múltiples especies.
La falta de este gen provoca una enfermedad llamada oligoastenoteratospermia u OAT, que afecta a la concentración, la movilidad y la morfología de los espermatozoides. Así mismo, evita que éstos puedan fecundar óvulos, causando así infertilidad en los hombres.
En el estudio de la WSU, los ratones macho que carecían de este gen producían un 28% menos de espermatozoides, que se movían 2,8 veces más despacio que en los ratones normales, y cerca del 98% de sus espermatozoides presentaban cabezas y piezas medias anormales.
La proteína codificada por este gen es necesaria para la producción normal de esperma. Por eso, el equipo de Oatley trabaja ya en el diseño de un fármaco que inhiba la producción o la función de esa proteína. Esto favorecería la anticoncepción masculina sin interferir en las hormonas.
Y es que, al alterar únicamente esta proteína, la testosterona no se vería afectada, lo que es importante, dado que, además de producir esperma, la testosterona se encarga también de la formación de masa ósea y fuerza muscular, y de producir glóbulos rojos.
Reversibilidad como anticonceptivo masculino
El diseño de un fármaco dirigido a esta proteína también facilitaría su reversibilidad como anticonceptivo.
«No se trata de eliminar la capacidad de producir espermatozoides, sino de impedir que los que se producen lo hagan correctamente. En teoría, se podría retirar el fármaco y los espermatozoides empezarían a fabricarse de nuevo con normalidad», razona el investigador.
Oatley y la primera autora del estudio, Mariana Giassetti, han presentado una patente provisional para el desarrollo de un anticonceptivo masculino basado en este gen y la proteína que codifica.
Como el gen se encuentra en casi todas las especies de mamíferos, el hallazgo también es prometedor para su uso en animales como alternativa a la castración. Esta es, actualmente, una de las pocas maneras existentes para controlar la reproducción.
También podría utilizarse en la fauna salvaje cuando se quiera limitar la superpoblación de una especie.
En humanos, este fármaco ayudaría a controlar la reproducción. Aunque existen muchas formas de control de la natalidad para las mujeres, no siempre son eficaces ni están ampliamente disponibles. Más de la mitad de los embarazos en todo el mundo siguen siendo no deseados, según Naciones Unidas.
En el caso de los hombres, ahora mismo, no existe ningún método de anticoncepción más allá de la cirugía. «Solo un pequeño porcentaje de hombres opta por la vasectomía», recuerda Oatley.
«Si logramos convertir este descubrimiento en una solución anticonceptiva, podría tener repercusiones de gran alcance», concluye.
EFE/